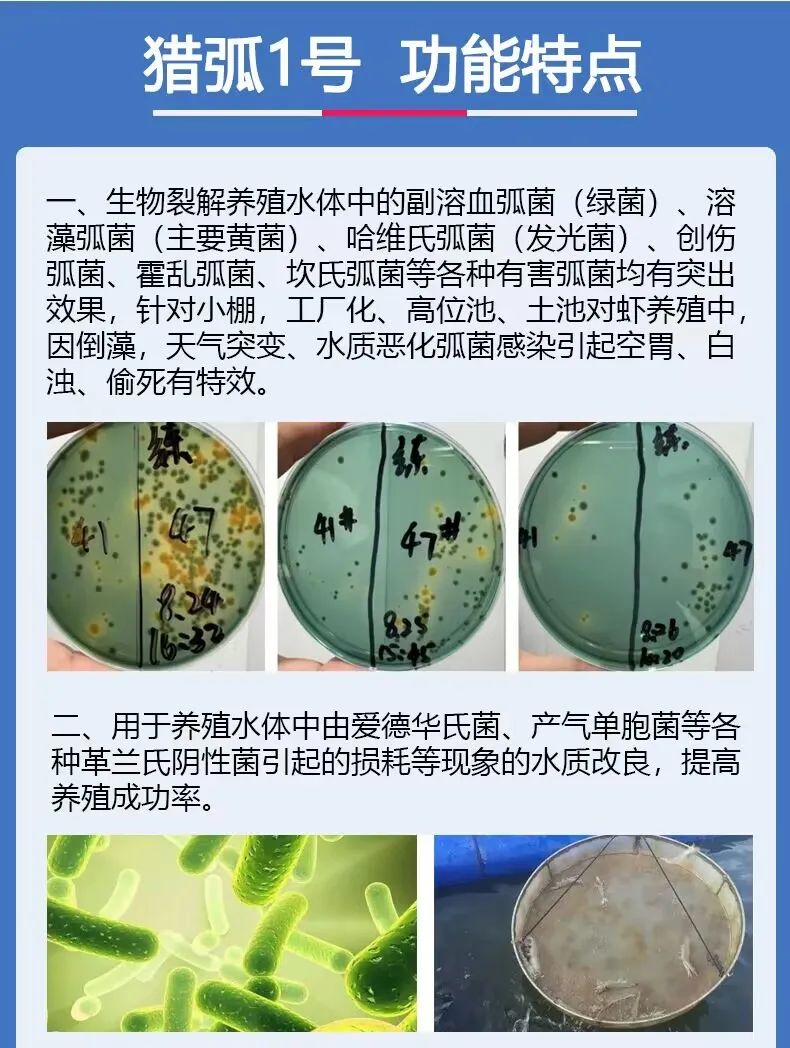

夏秋之交,水温高、光照强,弧菌与蓝藻两重大山,在对虾养殖成为拦路虎,如何在技术上有实破,国家实力的增强也为我们水产科研人才提供资金支持,广州顺州公司,采集中国沿海虾塘的高致命性弧菌,针对夏秋之间菌群种类的变化,研发出今年第三代生物猎杀包团,靶向对虾养殖中的有害弧菌进行围猎,对有益菌有保护增繁作用,在应用过程中发现,对虾塘的有害蓝藻明显有抑制作用,在当下的养殖季节,公司研发的猎弧1号值得使用。

| 发表评论 |
咨询:0779-2029779
随时,随地,伴你身边!
图文推荐
最新独家报道
今日要闻
热点推荐
X
